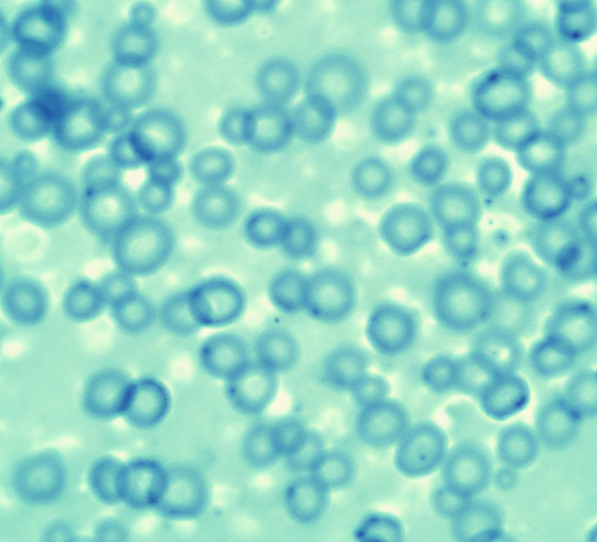

“조용히 나왔는데 냄새가 심해요. 혹시 건강 이상 신호일까요?”
“방귀에도 좋은 냄새, 나쁜 냄새가 있는 건가요?”
누구나 하루에 몇 번씩은 방귀를 뀝니다. 그런데 어떤 날은 냄새 없이 소리만 나는 방귀가 나오고, 또 어떤 날은 소리도 없이 고약한 냄새가 나곤 하죠. 이번 글에서는 방귀 냄새의 차이가 생기는 이유와, 건강과 어떤 관련이 있는지를 과학적 근거와 함께 알아보겠습니다.


목차
방귀는 왜 생기는 걸까?
방귀는 음식물 소화 과정에서 발생하는 가스가 장내 압력을 높이며 항문으로 배출되는 자연스러운 생리 작용입니다. 하루 평균 10~20회 정도 발생하며 대부분 무의식적으로 나옵니다.
• 공기 삼킴: 음식을 먹을 때 삼킨 공기가 위와 장을 통해 배출
• 장내 발효: 섬유소가 많은 음식을 섭취할 때 세균이 분해하면서 가스 발생
• 세균 대사: 장내 세균의 활동으로 메탄, 수소, 황화합물 등이 생성
• 이산화탄소: 위산과 중화작용 과정에서 생기는 부산물


방귀는 생존에 필수적인 장내 활동의 결과물이며, 건강한 장 기능의 일부로 간주할 수 있습니다.
냄새 없는 방귀와 냄새 나는 방귀의 차이
방귀는 다 같은 방귀가 아닙니다. 냄새의 유무는 방귀에 포함된 특정 화학 물질 때문이며, 그날 먹은 음식과 장내 상태에 따라 크게 달라집니다.
• 냄새 없는 방귀: 대부분 질소, 수소, 이산화탄소로 구성됨
• 냄새 나는 방귀: 황화수소(H₂S), 메탄티올 등 휘발성 황 화합물 포함
• 단백질 분해 과정: 육류, 달걀, 유제품 섭취 후 더 고약한 냄새
• 장내 세균 불균형: 유해균 증가 시 냄새가 더 강해짐



결국 방귀의 냄새는 장이 무엇을 어떻게 소화했는지 보여주는 지표라고 할 수 있습니다.
냄새 나는 방귀가 꼭 나쁜 건 아닙니다
방귀가 심하게 냄새난다고 해서 무조건 건강에 이상이 있다는 뜻은 아닙니다. 그러나 냄새가 갑자기 심해졌거나, 통증이나 설사를 동반한다면 체크가 필요합니다.
• 일시적 악취: 특정 음식 섭취 후 자연스러운 반응일 수 있음
• 만성적인 악취: 유당불내증, 과민성장증후군, 대장염 등 가능성
• 복통, 설사 동반 시: 염증성 장질환, 세균 감염 검사 필요
• 지속적인 냄새 변화: 식단, 장내 세균 상태 점검 필요



증상이 없다면 대부분은 자연스러운 생리 현상이지만, 신체가 보내는 경고일 수 있으니 가볍게 넘기지 마세요.
방귀 냄새 줄이는 식습관과 생활 팁
방귀 냄새가 신경 쓰인다면 장내 환경을 개선하고 식단을 조절하는 것이 가장 확실한 방법입니다.
• 발효식품 섭취: 김치, 요구르트 등 유익균 섭취로 장내 균형 유지
• 식이섬유 증가: 장운동 활성화 및 유해균 억제
• 고단백 음식 섭취 조절: 과도한 고기 섭취 시 단백질 분해 부산물 증가
• 규칙적인 배변 활동: 장내 가스 체류 시간 줄이기



또한 탄산음료, 껌, 빨대 사용 등으로 공기를 삼키는 습관도 줄이면 전체 가스량을 줄이는 데 도움이 됩니다.
방귀와 장 건강의 상관관계
방귀는 단순한 생리 현상을 넘어 장내 미생물 활동과 식습관, 건강 상태를 반영하는 지표입니다.
• 유산균 부족: 방귀 횟수와 냄새 증가
• 장내 유해균 우세: 복통, 설사, 악취 동반
• 소화불량, 스트레스: 장운동 저하 및 가스 배출 이상
• 정상 장 환경: 가스 생성은 있으나 냄새는 약함

결국 건강한 방귀는 ‘없어야 하는 것’이 아니라, 무리 없는 빈도와 약한 냄새로 배출되는 것입니다.
방귀 냄새가 심한 이유? 장 건강이 보내는 신호 살펴보기
방귀 냄새가 심한 이유? 장 건강이 보내는 신호 살펴보기
"요즘 방귀 냄새가 유난히 독해져서 신경 쓰여요.""소화는 되는 것 같은데, 방귀 냄새가 너무 심하니까 혹시 몸에 문제 있는 건 아닐까 걱정돼요.""장 건강과 관련 있다는 말도 있던데, 정말 그런
blog.mercisox.com
'건강 & 피트니스' 카테고리의 다른 글
| 심장약 복용 중이라면 반드시 피해야 할 행동들 (잘못된 습관들) (0) | 2025.04.30 |
|---|---|
| 중성지방 수치 낮추고 싶다면? 꼭 챙겨야 할 음식 리스트 (0) | 2025.04.30 |
| 협심증 증상(심장 질환), 단순 스트레스와 헷갈리지 마세요 (0) | 2025.04.30 |
| 부정맥 치료방법 총정리: 약물부터 시술까지 (0) | 2025.04.29 |
| 허혈성심장질환이 위험한 이유와 예방법 (혈관이 막히기 전에 예방하세요) (0) | 2025.04.29 |
| 어지럼증 원인 중 가장 위험한 부정맥, 바로 알기 (0) | 2025.04.28 |
| 약 복용 시간을 놓쳤을 때, (하루 또는 일주일) 지나버렸다면 이렇게 대처하세요 (0) | 2025.04.28 |
| 부정맥 증상이 의심된다면 꼭 알아야 할 5가지 (0) | 2025.04.28 |